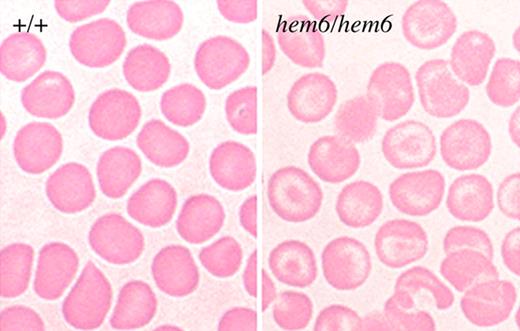
Figure 1. hem6 peripheral blood smear. Wright-Giemsa–stained peripheral blood smears demonstrating relatively prominent hypochromia with abundant target cells and minimal aniosopoikilocytosis in the mutant.

Abstract
Mouse models have proven invaluable for understanding erythropoiesis. Here, we describe an autosomal recessive, inherited anemia in the mouse mutant hem6. Hematologic and transplantation analyses reveal a mild, congenital, hypochromic, microcytic anemia intrinsic to the hematopoietic system that is associated with a decreased red blood cell zinc protoporphyrin to heme ratio, indicative of porphyrin insufficiency. Intercross matings show that hem6 can suppress the porphyric phenotype of mice with erythropoietic protoporphyria (EPP). Furthermore, iron uptake studies in hem6 reticulocytes demonstrate defective incorporation of iron into heme that can be partially corrected by the addition of porphyrin precursors. Gene expression and enzymatic assays indicate that erythroid 5-aminolevulinic acid synthase (Alas2) is decreased in hem6 animals, suggesting a mechanism that could account for the anemia. Overall, these data lead to the hypothesis that hem6 encodes a protein that directly or indirectly regulates the expression of Alas2.
Introduction
Erythroid maturation is a complex process coordinately regulated at multiple levels.1,2 An array of proteins act in a highly orchestrated manner to control the rapid, global changes in gene expression that occur during erythropoiesis. While the majority of genes are repressed in terminally differentiating erythroid cells, the cellular machinery involved in hemoglobin synthesis is rapidly activated.3 Coordinated porphyrin biosynthesis, iron acquisition, and globin protein production are required to ensure that these components accumulate in the proper stoichiometry to produce the end product, hemoglobin. In general, insufficiency of porphyrin, iron, or globin impairs hemoglobin production and results in a hypochromic, microcytic anemia.4,5
Heme, the prosthetic group of hemoglobin, is formed in a series of well-characterized catalytic steps that occur within and outside of mitochondria. The expression of all 8 heme biosynthesis enzymes is up-regulated in terminally differentiating erythroid cells,6 and erythroid-specific promoters that include GATA1 binding sites are present in most of the heme biosynthetic genes, including 5-aminolevulinic acid synthase 2 (Alas2), which contains several erythroid-specific transcription binding sites, enhancers and DNase hypersensitivity sites in the promoter, and several introns.5-7 Nonetheless, the absence of erythroid-specific promoters in the uroporphyrinogen decarboxylase (Urod) gene and the observation that GATA1 loss-of-function mutations do not reduce the protein levels of porphobilinogen deaminase (Pbgd) suggest that there are other unidentified, perhaps more universal, constituents of the porphyrin biosynthetic enzyme transcriptional regulatory machinery.8
ALAS2 and ferrochelatase (Fech) are also regulated at the translational level, either directly by intracellular iron or indirectly through iron-sulfur clusters or heme. The 5′ un-translated region (5′UTR) of the Alas2 mRNA contains an iron-responsive element (IRE), and iron regulatory proteins (IRPs) that bind this element can activate or inactivate ALAS2 translation according to the cellular iron or heme levels.9-11 The activity of mammalian ferrochelatase may be regulated by an iron-sulfur cluster at the C-terminus.12 In general, these posttranslational control mechanisms act to prevent excessive protoporphyrin IX (PPIX) accumulation when iron is limiting.
Normal iron metabolism is essential for a high level of heme production.5 Erythroid precursors are uniquely dependent upon the transferrin (Tf) cycle for delivery of iron sufficient for their heme biosynthetic needs.13 In the Tf cycle, diferric Tf (Fe2-Tf) bound to the Tf receptor (TfR) on the cell surface is endocytosed, and the endosome is acidified to release iron from Tf. Iron is then reduced to the Fe2+ form by Steap3,14-16 exported out of the endosome by divalent metal transporter 1(DMT1),17-19 and imported into the mitochondria by mitoferrin for heme synthesis.20 It has been suggested that the transport to mitochondria may require direct endosomal-mitochondrial contact.21
In this paper, we describe an inherited, autosomal recessive, hypochromic, microcytic anemia in the N-ethyl-N-nitrosourea (ENU)–induced mouse mutant hem6. Physiologic studies indicate that the anemia is due to a heme biosynthesis defect attributable to an abnormality in porphyrin synthesis related to the expression of Alas2. The mutant is genetically distinct from all the other known mouse microcytic anemia mutants and proteins previously implicated in heme biosynthesis or iron trafficking pathways, suggesting that it encodes a novel factor that normally acts to modulate porphyrin biosynthesis in erythroid cells.
Methods
Mice
The hem6 mutation was propagated from an ENU-mutagenized C57BL/6J (B6) male.22 Phenotyping, iron uptake, and heme synthesis studies were performed on a mixed background consisting of B6, 129P2/Ola (129P2), and 129S6/SvEvTac (129S6) at the [129P2 × B6] × 129S6F1 (129B6N2F1) generation. The allele was subsequently backcrossed onto 129S6 and B6. Hematologic parameters of the mutant on the 129B6N2F1, B6;129P2 (N6), and 129S6;B6 (N5) backgrounds are not qualitatively different from one another (data not shown). Genetic modifier analysis was performed on 129S6;B6-hem6 (N5) × 129S6;Balb/CJ-fechm1Pas (N5) at the F2 or F3 generations. Transplantation was performed with B6;129P2 (N6) animals segregating isozymes of glucose phosphate isomerase 1 (Gpi1a and Gpi1b).23 Animal procedures were approved by the Animal Care and Use Committee, Children's Hospital Boston.
Hematologic, transplantation, iron uptake, and heme synthesis analyses
Hematologic, transplantation, and iron analyses were performed as previously described.14 Alas activity in reticulocyte-rich blood was analyzed as described.24 May-Grünwald-Giemsa–stained (Sigma-Aldrich, St Louis, MO) peripheral blood smears were photographed on a Nikon Eclipse E600 microscope (Nikon, Garden City, NJ) with a 100×/0.30 numeric aperture oil-immersion lens and an RT Slider SPOT 2.3.1 camera (Diagnostic Instruments, Sterling Heights, MI) using SPOT Advanced software (version 3.5.9).
Flow cytometric analysis of erythrocyte fluorescence
Relative erythrocyte PPIX concentrations were determined on a EPICS ALTRA flow cytometer (Beckman Coulter, Porterville, CA) at an excitation wavelength of 488 nm and an emission wavelength of 650 nm.25
Genotyping and mapping
A total of 21 anemic [129P2 × B6]F2 intercross animals were used to map the hem6 locus using conventional polymerase chain reaction (PCR) genotyping techniques and the MapManager QTXb20 analysis program.26 Based upon these results, animals for phenotyping and other analyses were genotyped for the mutant B6 and wild-type 129S6/SvEvTac alleles at D3Mit101 and D3Mit346, which flank the hem6 locus centromerically and telomerically, respectively.
Results
hem6
The name hem6 derives from the sixth mutant with a hematologic abnormality identified in a mouse ENU mutagenesis screen.22 The trait is autosomal recessive, and the mutation is pleiotropic; the mice have anemia and male infertility, the latter due to a sperm defect morphologically characterized by abnormal cytoplasmic reduction of the neck of terminally differentiating spermatozoa, resulting in structural fragility and abnormal sperm motility (data not shown). The anemia phenotype will be the focus of this report.
Morphology of the hem6 anemia
Homozygous hem6 erythrocytes are hypochromic and mildly microcytic (Figure 1; Table 1). Target cells are prominent. A crystal violet stain of peripheral blood is negative for Heinz bodies, and siderocytes or ringed sideroblasts are not present on iron stains of the blood or bone marrow, respectively (data not shown). Similarly, transmission electron micrographs of red blood cells and spleen do not reveal protein aggregates indicative of Heinz bodies, nor are intramitochondrial electron-dense deposits characteristic of sideroblastic anemia present (data not shown). Hemoglobin electrophoresis on cellulose acetate gels demonstrates a wild-type pattern of globins and the α/β globin ratio is normal by high-performance liquid chromatography (HPLC), excluding a thalassemia or hemoglobinopathy (data not shown).
hem6 peripheral blood smear. Wright-Giemsa–stained peripheral blood smears demonstrating relatively prominent hypochromia with abundant target cells and minimal aniosopoikilocytosis in the mutant.
hem6 peripheral blood smear. Wright-Giemsa–stained peripheral blood smears demonstrating relatively prominent hypochromia with abundant target cells and minimal aniosopoikilocytosis in the mutant.
Hematologic parameters of hem6 and control animals
| Parameter . | 4 weeks . | 24 weeks . | ||||
|---|---|---|---|---|---|---|
| +/+ (n = 9) . | hem6/hem6 (n = 8) . | P . | +/+ (n = 10) . | hem6/hem6 (n = 8) . | P . | |
| WBCs, ×103/μL | 3.08 ± 1.22 | 3.94 ± 1.99 | .345 | 4.63 ± 1.14 | 6.06 ± 2.34 | .459 |
| RBCs, ×106/μL | 7.52 ± 0.62 | 9.59 ± 0.9 | < .001 | 9.59 ± 0.89 | 12.55 ± 2.13 | < .001 |
| Hemoglobin, g/dL | 128 ± 12 | 107 ± 10 | .002 | 136 ± 13 | 118 ± 21 | < .001 |
| Hematocrit, % | 46.5 ± 3.9 | 45.9 ± 5.2 | .803 | 50.7 ± 3.2 | 47.9 ± 6.3 | .075 |
| MCV, fL | 61.9 ± 1.9 | 47.7 ± 2.1 | < .001 | 53.3 ± 4.5 | 38.5 ± 1.9 | < .001 |
| MCH, pg | 17.0 ± 1.2 | 11.1 ± 0.9 | < .001 | 14.2 ± 9.4 | 9.4 ± 0.3 | < .001 |
| MCHC, g/dL | 275 ± 16 | 232 ± 24 | .003 | 266 ± 11 | 245 ± 15 | < .001 |
| RDW, % | 13.2 ± 0.9 | 18.2 ± 1.9 | < .001 | 13.8 ± 1.4 | 17.0 ± 0.5 | < .001 |
| Platelets, × 106/μL | 97.1 ± 11.7 | 91.0 ± 10.3 | .297 | 110.5 ± 12.4 | 100.2 ± 12.1 | .207 |
| MPV, fL | 7.5 ± 0.5 | 7.3 ± 0.7 | .651 | 7.4 ± 0.2 | 7.1 ± 10.4 | .236 |
| Reticulocytes, % | 7.7 ± 2.3 | 6.0 ± 1.7 | .13 | 2.1 ± 1.0 | 1.6 ± 0.4 | .408 |
| Abs retic, x106/μL | 5.7 ± 1.7 | 10.5 ± 12.0 | .342 | 2.01 ± 0.78 | 2.06 ± 0.66 | .655 |
| CHr, pg | 16.5 ± 0.3 | 12.7 ± 0.6 | < .001 | 15.2 ± 1.1 | 11.6 ± 0.5 | < .001 |
| ZnPP/H, μmol/mol | 105 ± 44 | 51 ± 12 | .010 | 64 ± 8 | 43 ± 6 | < .001 |
| Parameter . | 4 weeks . | 24 weeks . | ||||
|---|---|---|---|---|---|---|
| +/+ (n = 9) . | hem6/hem6 (n = 8) . | P . | +/+ (n = 10) . | hem6/hem6 (n = 8) . | P . | |
| WBCs, ×103/μL | 3.08 ± 1.22 | 3.94 ± 1.99 | .345 | 4.63 ± 1.14 | 6.06 ± 2.34 | .459 |
| RBCs, ×106/μL | 7.52 ± 0.62 | 9.59 ± 0.9 | < .001 | 9.59 ± 0.89 | 12.55 ± 2.13 | < .001 |
| Hemoglobin, g/dL | 128 ± 12 | 107 ± 10 | .002 | 136 ± 13 | 118 ± 21 | < .001 |
| Hematocrit, % | 46.5 ± 3.9 | 45.9 ± 5.2 | .803 | 50.7 ± 3.2 | 47.9 ± 6.3 | .075 |
| MCV, fL | 61.9 ± 1.9 | 47.7 ± 2.1 | < .001 | 53.3 ± 4.5 | 38.5 ± 1.9 | < .001 |
| MCH, pg | 17.0 ± 1.2 | 11.1 ± 0.9 | < .001 | 14.2 ± 9.4 | 9.4 ± 0.3 | < .001 |
| MCHC, g/dL | 275 ± 16 | 232 ± 24 | .003 | 266 ± 11 | 245 ± 15 | < .001 |
| RDW, % | 13.2 ± 0.9 | 18.2 ± 1.9 | < .001 | 13.8 ± 1.4 | 17.0 ± 0.5 | < .001 |
| Platelets, × 106/μL | 97.1 ± 11.7 | 91.0 ± 10.3 | .297 | 110.5 ± 12.4 | 100.2 ± 12.1 | .207 |
| MPV, fL | 7.5 ± 0.5 | 7.3 ± 0.7 | .651 | 7.4 ± 0.2 | 7.1 ± 10.4 | .236 |
| Reticulocytes, % | 7.7 ± 2.3 | 6.0 ± 1.7 | .13 | 2.1 ± 1.0 | 1.6 ± 0.4 | .408 |
| Abs retic, x106/μL | 5.7 ± 1.7 | 10.5 ± 12.0 | .342 | 2.01 ± 0.78 | 2.06 ± 0.66 | .655 |
| CHr, pg | 16.5 ± 0.3 | 12.7 ± 0.6 | < .001 | 15.2 ± 1.1 | 11.6 ± 0.5 | < .001 |
| ZnPP/H, μmol/mol | 105 ± 44 | 51 ± 12 | .010 | 64 ± 8 | 43 ± 6 | < .001 |
CBCs and RBC zinc ratios of protoporphyrin to heme (ZnPP/H) were determined in 129B6N2F1-+/+ and -hem6/hem6 animals at 4 and 24 weeks of age. Values are presented as the mean plus or minus 1 SD. P values are reported for the 2-tailed Student t test. Italics indicate significant differences.
WBC indicates white blood cell; RDW, red cell distribution width; MPV, mean platelet volume; Abs retic, absolute reticulocytes.
Complete blood counts and biometrics
Table 1 describes the complete blood counts (CBCs) and red blood cell (RBC) indices of 129B6N2F1 mutants and controls at 4 and 24 weeks of age. The mutants are mildly anemic and mutant erythrocytes are microcytic (mean corpuscular volume [MCV] decreased) and hypochromic (mean corpuscular hemoglobin concentration [MCHC] and reticulocyte hemoglobin content [CHr] decreased). The RBC number is increased, which is a common feature of microcytic anemias. There is no consistent difference in organ weight to body weight ratios, save trends toward proportionally larger testes and kidneys in mutants at 4 and 24 weeks of age (Table S1, available on the Blood website; see the Supplemental Materials link at the top of the online article). Splenomegaly was not present; however, histologic examination of the spleen showed slightly increased erythropoiesis (data not shown).
Mapping hem6
Using a reduced MCV and CHr as the defining features of the anemia, we mapped hem6 in 21 anemic [129P2 × B6] F2 animals to mouse chromosome 3 in the 12.4 centimorgan (cM) interval between the simple sequence length repeat (SSLR) markers D3Mit101 and D3Mit106 (D3Mit101—2.3 ± 2.3 cM—hem6—10.1 ± 5.2cM—D3Mit106—2.5 ± 2.5cM—D3Mit346). On the current consensus mouse genomic sequence (www.ensembl.org), this interval is 15.4 MB and includes 206 genes, but contains none of the currently identified genes for heme biosynthetic enzymes or proteins involved in iron metabolism. D3Mit103 and D3Mit206 were retrospectively and subsequently used to determine the hem6 genotype of animals used in all experiments.
Iron parameters
To evaluate the possibility that iron deficiency contributed to the anemia, we measured serum iron parameters and tissue iron stores (Table S2). The liver and serum iron parameters are not significantly different from those of wild-type littermates. However, at 4 and 24 weeks of age, respectively, there is slightly more and then less spleen iron in the mutants on a per-milligram of tissue basis.
Taken together, these findings argue against a thalassemia, unstable hemoglobin, redox defect, sideroblastic anemia, or iron deficiency as a cause of the hem6 anemia.
The hem6 anemia is transplantable
To determine whether an aspect of the hem6 anemia was due to an intrinsic, transplantable defect in hematopoietic cells, we transplanted fetal liver hematopoietic stem cells from embryonic day (E) 15.5 wild-type and hem6 donors into histocompatible wild-type recipients. Recipients and donors differed at the glucose-6-phosphate isomerase 1 (Gpi1) locus, allowing the extent of RBC chimerism to be assessed with an enzymatic assay.23 By 8 to 12 weeks, a stable, high-level chimerism was established in both groups (Figure 2; Table S3). The RBC indices of the mutant chimeras and older 129B6N2F1 mutants were similar. The reciprocal transplantation of wild-type fetal liver cells into mutant hosts demonstrated that wild-type hematopoietic cells are fully able to correct the hem6 anemia. These results support an intrinsic hematopoietic origin of the phenotype and exclude the possibility of a substantial component extrinsic to the hematopoietic system as a cause of the hem6 anemia.
The hem6 anemia is transplantable. Irradiated C57BL/6J-Igha Thy1a Gpi1 a +/+ or hem6/hem6 animals that had received C57BL/6J-Ighb Thy1b Gpi1b hem6/hem6 (n = 7; black lines) or +/+ (n = 8; gray lines) fetal liver cells, respectively, were serially monitored for RBC chimerism (dotted lines) by Gpi1 isozyme analysis and for blood parameters. The decrease (in the case of hem6 → +) or increase (in the case of + → hem6) in MCV (solid lines) closely follows engraftment by the donor cells. Error bars indicate plus or minus 1 SD.
The hem6 anemia is transplantable. Irradiated C57BL/6J-Igha Thy1a Gpi1 a +/+ or hem6/hem6 animals that had received C57BL/6J-Ighb Thy1b Gpi1b hem6/hem6 (n = 7; black lines) or +/+ (n = 8; gray lines) fetal liver cells, respectively, were serially monitored for RBC chimerism (dotted lines) by Gpi1 isozyme analysis and for blood parameters. The decrease (in the case of hem6 → +) or increase (in the case of + → hem6) in MCV (solid lines) closely follows engraftment by the donor cells. Error bars indicate plus or minus 1 SD.
Evidence for a defect in erythroid heme synthesis
Unlike most hypochromic, microcytic anemias, hem6 animals have a decrease in the zinc protoporphyrin IX (ZnPP) to heme (ZnPP/H) ratio (Table 1). ZnPP is a normal metabolite formed in trace amounts by the incorporation of Zn2+, rather than Fe2+, into PPIX by ferrochelatase. Elevated levels of erythrocyte ZnPP/H are characteristic of iron deficiency and lead poisoning and may also be seen in situations of rapid iron turnover, as in the thalassemias.27 In hem6 RBCs, however, the ZnPP/H is decreased compared with control animals; at 24 weeks of age, the ZnPP/H is only two-thirds that of control animals. This result strongly argues against actual or functional iron deficiency as a cause of the anemia, and suggests an abnormality in porphyrin biosynthesis.
hem6 reticulocytes are defective in heme production but not iron uptake
To test the hypothesis that the hem6 hemoglobin deficiency was due to abnormal heme synthesis in the RBC precursor, we examined iron uptake and heme production in mutant and wild-type reticulocytes. Reticulocyte-rich blood from serially bled animals was incubated with 55Fe2-Tf, and the fraction of the total intracellular iron incorporated into heme was measured. Although the total cellular iron uptake was not different between the mutants and the controls (Figure 3A), the absolute heme iron and the fraction of cellular iron incorporated into heme were significantly lower in mutant reticulocytes (Figure 3B). The ZnPP/heme data did not support mitochondrial iron deficiency; nonetheless, we attempted to correct the heme synthesis defect by treating the reticulocytes with 55Fe complexed to the weak lipophilic chelator salicylaldehyde isonicotinoyl hydrazone (SIH), which delivers iron for heme synthesis in a transferrin cycle–independent manner.28 55Fe-SIH treatment of mutant reticulocytes did not alter the fraction of iron used for heme synthesis (Figure S1), further suggesting that an iron uptake defect was not responsible for the hem6 heme deficiency and anemia.
hem6 reticulocytes have a defect in iron incorporation into heme partially corrected by ALA. (A) Reticulocyte iron uptake and heme biosynthesis were measured in 129B6N2F1hem6/hem6 (n = 4; ■) and +/+ (n = 4; ▩) control littermates following 30 minutes of incubation with 55Fe2-transferrin with or without 2 mM added ALA. The data are normalized to and presented as uptake per microgram of RNA per hour. (B) Average heme iron to whole-cell iron ratio from 3 independent experiments with or without ALA treatment is shown. Error bars represent plus or minus 1 SD.
hem6 reticulocytes have a defect in iron incorporation into heme partially corrected by ALA. (A) Reticulocyte iron uptake and heme biosynthesis were measured in 129B6N2F1hem6/hem6 (n = 4; ■) and +/+ (n = 4; ▩) control littermates following 30 minutes of incubation with 55Fe2-transferrin with or without 2 mM added ALA. The data are normalized to and presented as uptake per microgram of RNA per hour. (B) Average heme iron to whole-cell iron ratio from 3 independent experiments with or without ALA treatment is shown. Error bars represent plus or minus 1 SD.
ALA partially corrects the hem6 heme iron incorporation defect
To specifically address the possibility that a defect in porphyrin synthesis existed in hem6 reticulocytes, we performed radioactive heme synthesis experiments in the presence of added ALA, which is the product of the first step of the heme biosynthetic pathway. Addition of exogenous ALA stimulates 55Fe incorporation into heme in mutant, but not wild-type, reticulocytes, measured as an overall increase in the fraction of reticulocyte iron incorporated into heme in the mutant cells (Figure 3B). Similar results were obtained when PPIX was preincubated with mutant reticulocytes (data not shown).
The hem6 allele modifies the erythropoietic protoporphyria phenotype of fechm1Pas animals
To further confirm that the hem6 anemia results from an abnormality in the porphyrin biosynthesis pathway, we crossed hem6 animals to fechm1Pas animals that have a recessive loss-of-function mutation in Fech, the gene encoding terminal enzyme in heme biosynthesis, ferrochelatase. Homozygous fechm1Pas animals have dramatically elevated levels of PPIX in mutant erythrocytes, plasma, liver, and feces, mimicking human erythropoietic protoporphyria (EPP).29
Using flow cytometry, we determined the relative fluorescence (indicative of the relative accumulation of PPIX) of RBCs from hem6 × fechm1Pas intercross animals. Compared with fechm1Pas/m1Pas homozygotes, which have 34.8% plus or minus 16.9% of RBCs in the fluorocyte gate, the hem6/hem6 fechm1Pas/m1Pas double homozygotes have 2.4% plus or minus 1.7% fluorocytes, which is more similar to control animals (Figure 4A,B). Furthermore, whereas fechm1Pas/m1Pas animals exhibit hepatomegaly due to hepatic porphyrin accumulation, the liver–body weight ratio is indistinguishable between the double homozygotes and their control littermates (Figure 4C). At 12 weeks of age, the total liver PPIX is approximately 2.5-fold less in the double mutants compared with fechm1Pas/m1Pas animals (data not shown). The reduced PPIX accumulation may be due to an increase in the ferrochelatase activity or a decrease in PPIX biosynthesis. Hematologic data support the latter possibility, in particular, as the double mutant animals develop a microcytic anemia comparable with that of hem6 homozygotes (Figure 4D; Table S4), and suggest that hem6 is genetically “upstream” of Fech.
hem6 modifies erythropoietic protoporphyria. (A) Flow cytometric analysis of erythroid PPIX levels in 129S6;C- fechm1Pas/+ × 129S6;B6-hem6 intercross offspring, showing a representative set of 3 animals with key genotypes. Numbers in the upper left corner of each scattergram represent the percentage of cells in the fluorocyte gate. The horizontal lines separate the positive gate (above the line) from the negative gate (below the line). (B) Histogram of the average fluorocyte percentage. (C) Liver–body weight ratios of selected genotypes. (D) Hemoglobin levels of selected genotypes. All error bars represent plus or minus 1 SD.
hem6 modifies erythropoietic protoporphyria. (A) Flow cytometric analysis of erythroid PPIX levels in 129S6;C- fechm1Pas/+ × 129S6;B6-hem6 intercross offspring, showing a representative set of 3 animals with key genotypes. Numbers in the upper left corner of each scattergram represent the percentage of cells in the fluorocyte gate. The horizontal lines separate the positive gate (above the line) from the negative gate (below the line). (B) Histogram of the average fluorocyte percentage. (C) Liver–body weight ratios of selected genotypes. (D) Hemoglobin levels of selected genotypes. All error bars represent plus or minus 1 SD.
Decreased Alas2 expression can account for the hem6 heme synthesis defect
Overall, the data support the hypothesis that the hem6 mutation impairs porphyrin synthesis in the erythron. In order to further evaluate this notion, using extraction, HPLC separation, and detection methods sensitive to products distal to porphobiliogen in the heme biosynthetic pathway (ie, tetrapyrroles), we did not detect a difference in profiles of porphyrin precursors derived from hem6 and control livers and erythrocytes (data not shown), as might be expected if there were a block at an individual enzymatic or transport step distal to the assembly of the tetrapyrrole ring. Based on this observation, we reasoned that the defect in heme biosynthesis in hem6 erythroid cells most likely lay in a synthesis or transport step more proximal in the pathway.
Because ALA synthesis is regarded as the rate-limiting step in heme biosynthesis in erythroid cells,30 we first considered the possibility that a decrease in Alas enzymatic activity could account for the phenotype. Comparison of Alas (Alas1 + Alas2) activity in mutant and wild-type reticulocyte-rich blood indicated a 38% reduction in the mutant compared with the wild-type (Figure 5). Furthermore, quantitative reverse transcription (RT)–PCR on these same samples demonstrated an 82% reduction in the relative amount of Alas2 mRNA in the mutant. The discrepancy between the Alas enzymatic activity and Alas2 mRNA can in part be accounted for by a nearly 5-fold up-regulation of Alas1 mRNA (data not shown). Quantitative RT-assays of mRNA encoding the 2 subsequent enzymes in the heme biosynthetic pathway, ALA dehydrogenase and porphobilinogen deaminase revealed that these mRNAs were not reduced in the mutant (data not shown), indicating the specificity of the effect on Alas2.
hem6 reticulocytes are Alas2 deficient. Alas (Alas1 + Alas2) enzymatic activity normalized to reticulocyte RNA content, Alas2 mRNA levels normalized to β-actin mRNA levels, and the ratio of normalized Alas activity to normalized Alas2 mRNA. Each value is expressed in arbitrary units plus or minus 1 SD.
hem6 reticulocytes are Alas2 deficient. Alas (Alas1 + Alas2) enzymatic activity normalized to reticulocyte RNA content, Alas2 mRNA levels normalized to β-actin mRNA levels, and the ratio of normalized Alas activity to normalized Alas2 mRNA. Each value is expressed in arbitrary units plus or minus 1 SD.
Discussion
We have described the phenotype and pathogenesis of the anemia in the hem6 microcytic anemia mutant. To summarize, transplantation studies, and a decreased erythrocyte ZnPP/heme ratio and normal reticulocyte iron uptake in the setting of impaired iron incorporation into heme provided evidence that the mutation impairs porphyrin synthesis in erythroid cells. These observations were supported by data showing that porphyrin precursor supplementation in reticulocyte heme synthesis assays mitigated the defect. Furthermore, the hem6 allele suppressed the EPP phenotype of fechm1Pas mice. Several observations suggest that the level of the heme synthesis defect may be early in the pathway. First, we did not detect an accumulation of tetrapyrroles in the erythrocytes or the liver of hem6 animals, as would be typical of the classical porphyrias. Second, as ALA partially complements the defect and there is a deficiency of Alas activity and Alas2 mRNA in the mutant, it would appear that a substantial, but not necessarily exclusive, pathophysiology of the hem6 anemia lies in erythroid ALA insufficiency.
Unlike the other heme biosynthesis enzymes, many of which have erythroid-specific isoforms or promoters, erythroid precursors are largely dependent on a distinctive X-linked gene encoding an erythroid-specific isoform of Alas, Alas2. Mutations in ALAS2 in humans result in X-linked sideroblastic anemia (XLSA), characterized by a hypochromic, microcytic anemia with pathologic intramitochondrial iron deposits in erythroid precursors in the bone marrow and enucleated erythrocytes in the peripheral blood30 —so-called ringed sideroblasts and siderocytes, respectively.31,32 Although hem6 animals have a deficiency of Alas activity and Alas2 mRNA, we did not observe sideroblasts or siderocytes. Several differences between the mouse and human disorders may account for this discrepancy. First, in hem6 animals, the loss of Alas activity is modest, decreased by nearly 50%. By comparison, patients with XLSA typically have severely (> 90%) decreased bone marrow ALAS activity.30 Second, targeted disruption of the Alas2 gene in mice sometimes leads to cytosolic iron overload with relatively modest intramitochondrial iron accumulation, which is distinctively different from the human phenotype.33,34 Last, drugs or nutritional states such as isoniazid toxicity or pyrdoxine (vitamin B6) deficiency that characteristically lead to sideroblastic anemias in people present as siderocytic anemias in mice,35 perhaps due to the fact that a substantially greater fraction of heme synthesis occurs in enucleated erythrocytes in mice compared with humans.36 On these grounds, it might be suggested that a comparable insult in humans would give rise to a sideroblastic anemia, but the mouse is relatively resistant to the development of siderocytes and sideroblasts due to physiologic differences between the 2 species.
One interesting feature of the hem6 phenotype is the disproportionate preservation of Alas enzymatic activity compared with the Alas2 mRNA levels (Figure 5). This could be accounted for by compensatory expression of the housekeeping form of the enzyme, Alas1, whose mRNA is increased 5-fold in mutant reticulocytes. Alternatively, this effect could be due to translational control of Alas2 protein synthesis, postulated to be mediated by the IRE in the 5′UTR of the Alas2 mRNA.37,38 Recently, for example, it has been shown that a defect in the mitochondrial biosynthesis of iron-sulfur clusters results in inappropriate repression of translation of Alas2 mRNA mediated through the 5′ IRE.9
A large number of studies of Alas2 transcription have lead to the identification of alternative splice isoforms,39 erythroid transcription factor binding sites in the promoter,40 and an enhancer located in intron 8.41 Other DNase I hypersensitive sites have also been mapped to introns 1 and 3.7,40 By contrast, Alas2 mRNA stability has not been studied systematically. In the future, we will clarify whether the decreased Alas2 mRNA level in hem6 reticulocytes is a result of decreased transcription or decreased mRNA stability.
Although we have not studied the hem6 sperm defect in great detail, it is difficult to reconcile the infertility phenotype with a “pure” heme biosynthesis defect; heme biosynthesis abnormalities are not known to be associated with defective spermatogenesis or sperm function. On this basis, we suggest that it is entirely possible that the hem6 mutation is in a protein that modulates several different pathways, such as a signaling molecule, or transcription factor, or that it is a contiguous gene syndrome, such as the nm1054 phenotype that we recently reported.14,15 However, this latter possibility is unlikely if the mutation did indeed arise as a result of ENU treatment, which typically results in single-nucleotide substitutions. Ongoing mapping studies eventually leading to the identification of the hem6 gene will settle this question. Furthermore, functional characterization of the hem6 protein product will further illuminate the pathogenesis of the anemia and the regulation of heme biosynthesis in erythroid cells.
The online version of this article contains a data supplement.
The publication costs of this article were defrayed in part by page charge payment. Therefore, and solely to indicate this fact, this article is hereby marked “advertisement” in accordance with 18 USC section 1734.
Acknowledgments
The authors thank Terence Law, Jane-Jane Chen, and An-Ping Han for technical advice; and Nancy Andrews and members of her laboratory as well as Lance Lee, Steve Margossian, and Marian Harris for ongoing constructive criticism of the project. We thank Prem Ponka for the gift of SIH.
M.D.F. is supported by National Institutes of Health (NIH) grants R01 HL074247 and R01 DK062474 and the Roche Foundation for Anemia Research (RoFAR). M.J.J. is supported by NIH grants R01 CA115503 and U01 HD39372.
National Institutes of Health
Authorship
Contribution: M.T. designed all experiments, performed all functional studies, and contributed to the writing of the manuscript; D.C. performed husbandry and technical support; L.W. performed initial characterization and mapping studies; M.J.J. supervised the mutagenesis and mapping project and contributed to the manuscript; and M.D.F. supervised functional characterization secondary mapping studies and contributed to the manuscript.
Conflict-of-interest disclosure: The authors declare no competing financial interests.
Correspondence: Mark D. Fleming, Department of Pathology, Enders 1116.1, Children's Hospital Boston, 300 Longwood Avenue, Boston, MA 02115; e-mail: mark.fleming@childrens.harvard.edu.

This feature is available to Subscribers Only
Sign In or Create an Account Close Modal